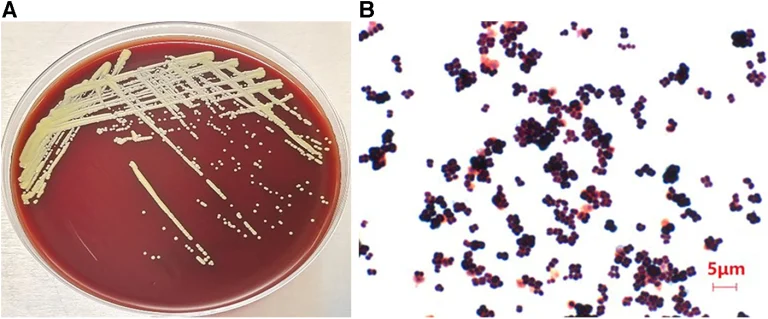

Микрококкын нянгийн халдвар
Micrococcus Infection (english)
Противо-Микрококковые природные антибиотики (ру́сский)
Микрококкын нян нь голдуу арьс, салт бүрхэвч, ам-залигуурын эд эст үүрлэдэг.
Үндсэн зовуурь, шинж тэмдэг (болзошгүй хожмын үеийн)
Энэ зовиур эмгэгийн үед дараахь гол шинж тэмдэг, симптомууд илэрдэг.
Зохимжтой ба зохимжгүй бүтээгдэхүүн
Хэрэглэх, эс хэрэглэх бүтээгдэхүүнүүд